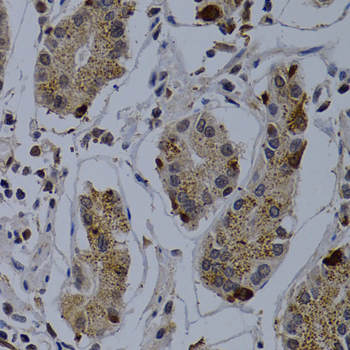

For quotations, please use our online quotation form, and you may also contact us by
sales@neoscientific.com
+1-888.733.6849
+1-617.299.7367 (Int’l)
+1-888.733.6849
+1-617.299.7367 (Int’l)
| Reactivity | Human Rat |
| Tested applications | WB IHC |
| Recommended Dilution | WB 1:500 - 1:2000 IHC 1:50 - 1:200 |
| Calculated MW | 33kDa |
| Observed MW | Refer to Figures |
| Immunogen | Recombinant protein of human TNFRSF6B |
| Storage Buffer | Store at -20℃. Avoid freeze / thaw cycles. Buffer: PBS with 0.02% sodium azide, 50% glycerol, pH7.3. |
| Concentration | bp |
| Synonym | TNFRSF6B;DCR3; TR6 |

Western blot analysis of extracts of various cells, using TNFRSF6B antibody.

Immunohistochemistry of paraffin-embedded rat kidney using TNFRSF6B antibody at dilution of 1:200 (400x lens).

Immunohistochemistry of paraffin-embedded human kidney cancer using TNFRSF6B antibody at dilution of 1:200 (400x lens).
Immunohistochemistry of paraffin-embedded human normal stomach using TNFRSF6B antibody at dilution of 1:200 (400x lens).
The tumor necrosis factor receptor family, which includes TNF-RI, Fas, DR3, DR4, DR5, and DR6, plays an important role in the regulation of apoptosis in various physiological systems (1,2). The receptors are activated by a family of cytokines that include TNF, FasL, and TRAIL. They are characterized by a highly conserved extracellular region containing cysteine-rich repeats and a conserved intracellular region of about 80 amino acids termed the death domain (DD). The DD is important for transducing the death signal by recruiting other DD containing adaptor proteins (FADD, TRADD, RIP) to the death-inducing signaling complex (DISC), resulting in activation of caspases. Death receptor signaling is also controlled by a family of decoy receptors (DcR1, DcR2 and DcR3) which lack a cytoplasmic DD and inhibit death receptor-mediated apoptosis by competing for ligand (3-5). Expression of decoy receptors provide a mechanism for certain types of cancer to regulate apoptosis and can contribute to chemosensitivity (6-8).
N/A